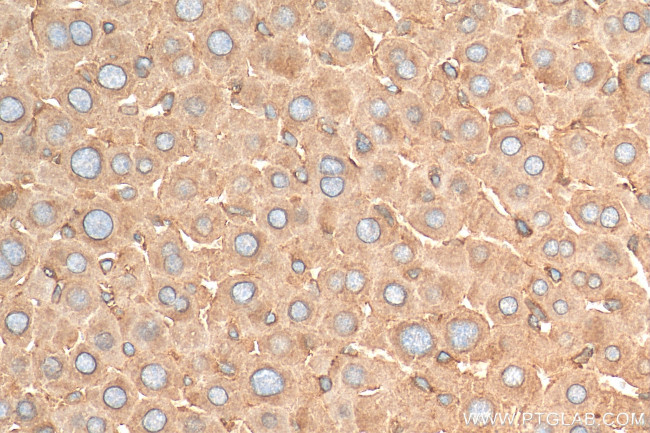
GPC3 Antibody in Immunohistochemistry (Paraffin) (IHC (P))

Search
Proteintech
GPC3 Polyclonal Antibody
{{$productOrderCtrl.translations['antibody.pdp.commerceCard.promotion.promotions']}}
{{$productOrderCtrl.translations['antibody.pdp.commerceCard.promotion.viewpromo']}}
{{$productOrderCtrl.translations['antibody.pdp.commerceCard.promotion.promocode']}}: {{promo.promoCode}} {{promo.promoTitle}} {{promo.promoDescription}}. {{$productOrderCtrl.translations['antibody.pdp.commerceCard.promotion.learnmore']}}
产品信息
30021-1-AP
种属反应
宿主/亚型
分类
类型
抗原
偶联物
形式
纯化类型
保存液
内含物
保存条件
运输条件
产品详细信息
Immunogen sequence: VAENDTLCWN GQELVERYSQ KAARNGMKNQ FNLHELKMKG PEPVVSQIID KLKHINQLLR TMSMPKGRVL DKNLDEEGFE SGDCGDDEDE CIGGSGDGMI KVKNQLRFLA ELAYDLDVDD APGNSQQATP KDNEISTFHN
靶标信息
GPC3 is a cell surface proteoglycan that bears heparan sulfate. This protein may be involved in the suppression/modulation of growth in the predominantly mesodermal tissues and organs, and may play a role in the modulation of IGF2 interactions with its receptor and thereby modulate its function. Members of the glypican-related integral membrane proteoglycan family contain a core protein anchored to the cytoplasmic membrane via a glycosyl phosphatidylinositol (GPI) linkage. These proteins may play a role in the control of cell division, growth regulation, and tumor predisposition. Deletion mutations in GPC3 are the cause of Simpson-Golabi-Behmel syndrome (SGBS), also known as Simpson dysmorphia syndrome (SDYS). SGBS is a condition characterized by pre- and postnatal overgrowth (gigantism) with visceral and skeletal anomalies.
仅用于科研。不用于诊断过程。未经明确授权不得转售。
篇参考文献 (0)
生物信息学
蛋白别名: cell surface protein; precursor core protein cleaved by furin; glypican proteoglycan 3; Glypican-3; GTR2-2; GTR22; heparan sulphate proteoglycan; Intestinal protein OCI-5; MXR7; OCI-5; secreted glypican-3; unnamed protein product
基因别名: DGSX; GPC3; GTR2-2; MXR7; OCI-5; OCI5; SDYS; SGB; SGBS; SGBS1
UniProt ID: (Human) P51654, (Mouse) Q8CFZ4
Entrez Gene ID: (Human) 2719, (Mouse) 14734